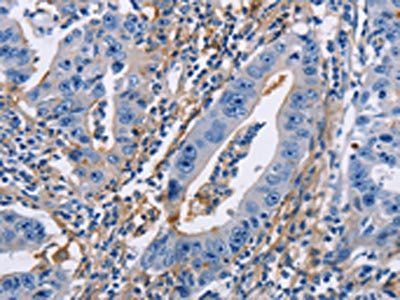
ICAM1 Antibody

You have no items in your shopping cart.
Search results for: 'ICAM-1 (CD54)'
- ICAM1 Recombinant Monoclonal Antibody [orb688953]
ELISA, FC, IHC
Human
Monoclonal
Unconjugated
100 μl, 50 μl - ICAM1 Antibody [orb627894]Featured

ELISA, IF, IHC, IP, WB
Mouse, Rat
Rabbit
Polyclonal
Unconjugated
100 μg, 50 μg - ICAM-1 (phospho Tyr512) rabbit pAb [orb764208]Featured

ELISA, WB
Human, Mouse, Rat
Polyclonal
Unconjugated
100 μl, 50 μl - CD54 / ICAM-1 Antibody [orb1410429]
IHC
Human
Mouse
Monoclonal
Unconjugated
100 μg (without BSA and Azide), 100 μg, 20 μg - CD54 Antibody [orb1474641]
IF, IHC, WB
Human, Mouse, Rat
Rabbit
Polyclonal
Unconjugated
50 μl, 100 μl, 200 μl, 30 μl - CD54 / ICAM-1 Antibody [orb2309960]
IHC
Human
Mouse
Monoclonal
Unconjugated
100 μg (without BSA and Azide), 100 μg, 20 μg